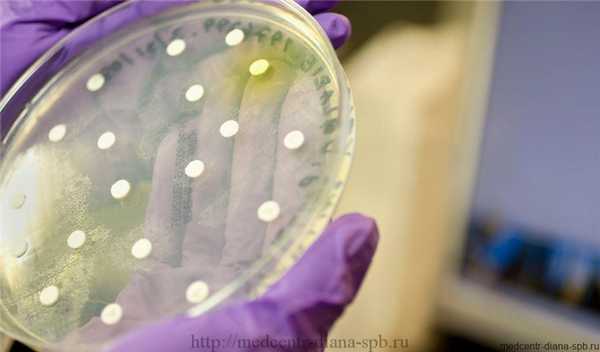
Главный женский анализ — мазок на флору: просто о сложном

Мазок на флору. Показатели влагалищного мазка в норме и при патологии
Добавил пользователь Валентин П. Обновлено: 31.01.2026
Анализы на степень чистоты влагалища у женщины - это определение количества и соотношения нормальной, условно-патогенной и патогенной микрофлоры и клеточных элементов с помощью световой микроскопии. Современный алгоритм лабораторной оценки вагинальной микрофлоры предусматривает четыре степени "чистоты влагалища" на основании микроскопии мазков, окрашенных по Граму - это 1, 2, 3 и 4. Применяется в практической работе во многих лабораториях Москвы и других регионов России.
Степени чистоты мазка на флору
1. Классическая оценка степени чистоты влагалища
| Степень чистоты | Лабораторные признаки |
|---|---|
| 1 | обнаруживаются грам+ палочки ("палочки Дедерлейна", они же "влагалищные" или "вагинальные" палочки) и скудное количество клеток плоского эпителия |
| 2 | присутствует небольшое количество посторонних бактерий (кокков) при преобладании грам+ палочек |
| 3 | при 3 степени чистоты мазка в флоре преобладает кокковая флора, присутствуют лейкоциты в значительном количестве |
| 4 | 4 степень чистомы мазка имеет признаки: палочки Дедерлейна" практически полностью отсутствуют, имеется в значительном количестве "посторонняя" микрофлора, очень большое количество лейкоцитов |
2. Определение степени чистоты мазка из влагалища согласно лактобациллярному алгоритму
| Степень | Характерные признаки |
|---|---|
| I | Преимущественно лактобациллярные морфотипы, с незначительным количеством кокков |
| II А | Лактобациллярные морфотипы и значительное количество кокковой флоры,но количество лактобацилл превышает количество кокков |
| II В | Лактобациллярные морфотипы и значительное количество кокковой флоры,но количество кокков превышает количество лактобацилл |
| III | Присутствие коккоподобной флоры и отсутствие лактобацилл |
3. Оценка биоценоза влагалища по мазку на степень чистоты (Е.Ф.Кира, 1996), актуальный алгоритм.
Мазок 1 степени чистоты
«Нормоценоз»
| Признаки | Результат |
|---|---|
| Доминирование лактобацилл, отсутствие грам"-" флоры, спор, мицелия, псевдогифов, лейкоцитов, единичные “чистые” эпителиальные клетки. | Типичное состояние нормального биотопа влагалища. |
Мазок 2 степени чистоты
«Промежуточный тип»
| Признаки | Результат |
|---|---|
| Умеренное или незначительное количество лактобацилл, наличие грамположительных кокков, грамотрицательных палочек. Обнаруживаются лейкоциты, макрофаги, эпителиальные клетки. | Часто наблюдается у здоровых женщин, редко сопровождается субъективными жалобами и клиническими проявлениями. |
3 степень чистоты мазка А
«Дисбиоз влагалища»
| Признаки | Результат |
|---|---|
| Незначительное количество, но чаще полное отсутствие лактобацилл, обильная, полиморфная грамотрицательная и грамположительная палочковая и кокковая микрофлора. Наличие "ключевых клеток", количество лейкоцитов вариабильно, отсутствие или незавершенность фагоцитоза. Полимикробная картина мазка. | Бактериальный вагиноз. |
3 степень чистоты мазка Б
«Вагинит»
| Признаки | Результат |
|---|---|
| Большое количество лейкоцитов (до 100-150), макрофагов, эпителиальных клеток, выраженный фагоцитоз. | Неспецифический вагинит. |
4 степень чистоты мазка
«Кольпит»
| Признаки | Результат |
|---|---|
| При обнаружении гонококков трихомонад мицелия, псевдогифов, спор.Лейкоциты - сплошь покрывают поля зрения | Специфический вагинит: Гонорея Трихомониаз Микотический вагинит. |
Расшифровка мазка на степень чистоты
Показатели чистоты гинекологического мазка 1 и 2 являются показателями здоровья, т.е. нормы. Мазок из влагалища 3 и 4 степени чистоты говорит о наличии у женщины кольпита - воспаления влагалища.
Для уточнения причин, почему гинекологический мазок на флору показывает 3 и 4 степень чистоты должны быть назначены анализы на инфекции (ПЦР, посевы, ИФА) согласно стандартным алгоритмам лабораторной диагностики.
Узнать, как лечить 3, 4 степень чистоты мазка можно на странице сервиса дистанционной гинекологии (услуга платная!).

Где сдать этот анализ
Сдать мазки на степень чистоты в Москве можно в нашей клинике на Кутузовском проспекте рядом с метро. Взятие материала ежедневно, с 10-00. Стоимость анализа 500 - 550 рублей, взятие оплачивается отдельно - цена 550 рублей (включая одноразовые расходные материалы).
121165 , Москва , Кутузовский проспект, 33

Копирование и воспроизведение материалов данного сайта запрещено. Информация, представленная на любой странице данного сайта в том или ином виде, носит исключительно информационный, рекомендательный характер и не может заменить очной консультации у врача относительно показаний и вероятных противопоказаний. Условия и порядок оказания любых сервисных и медицинских услуг (включая, но не ограничиваясь - цены, перечень, акции, скидки) не являются публичной офертой (ст. 437 ГК РФ). По всем вопросам просьба контактировать с рецепшн. ООО «Центр Женского Здоровья» © 1999—2022гг.
Какой мазок считается нормальным
Мазки - один из самых распространенных методов диагностики инфекций у женщин. Этот анализ совершенно безопасен и безболезнен для пациентки и определенно информативен для врача гинеколога. На его основе могут проводиться два основных теста: исследование состава микробной флоры и определение степени чистоты влагалища.
Результаты мазка на инфекции у здоровых женщин и девушек подразумевают наличие следующих показателей:
Плоский эпителий - слой клеток, выстилающий влагалище и шейку матки. В нормальном мазке эпителий должен присутствовать. Если же мазок эпителий не содержит, то у врача-гинеколога есть основание предположить недостаток эстрогенов, избыток мужских половых гормонов. Отсутствие плоского эпителия в мазке свидетельствует об атрофии эпителиальных клеток.
Лейкоциты - в норме до 15 единиц в поле зрения. Небольшое количество лейкоцитов выполняют защитную функцию, препятствуют проникновению инфекции в половые органы женщины. Повышенное их число наблюдаются при воспалении влагалища (кольпит, вагинит). Чем больше их в мазке, тем острее протекает заболевание.
Золотистый стафилококк в небольших количествах - норма мазка. Значительное повышение стафилококка в мазке, как и повышение лейкоцитов в мазке, может быть симптомом воспалительного процесса во влагалище (кольпит), слизистой оболочки матки (эндометрит).
Палочки в мазке составляют нормальную микрофлору влагалища. Кроме палочек в мазке в норме не должно быть других микроорганизмов.
Норма мазка у женщин - таблица
| Показатели | Влагалище | Шейка матки | |
|---|---|---|---|
| лейкоциты | 0-15 | 0-25 | |
| эпителий | зависит от фазы менструального цикла | ||
| слизь | умеренно | умеренно | |
| гонококки | нет | нет | |
| трихомонады | нет | нет | |
| ключевые клетки | нет | нет | |
| кандиды | нет | нет | |
| микрофлора | много грам+ палочек | отсутствует | |
Ниже в таблице приведен пример нормального женского мазка на флору. Обращаем Ваше внимание на то, что приведенные цифры являются лишь иллюстрацией одного из возможных многочисленных вариантов "здорового" мазка. Конечная интерпретация результатов гинекологических исследований, установление диагноза в соответствии с Федеральным законом № 323-ФЗ «Об основах охраны здоровья граждан. » от 21.11.2011г, может производиться только врачом соответствующей специализации.
Расшифровка мазка
Результат анализа мазка на флору подразумевает обычно формулировку - "хороший" или "плохой". Сдача его не представляет трудностей для пациентки, но чтобы провести забор и получить достоверный результат, гинекологу и врачу-лаборанту потребуется высокая квалификация. В противном случае расшифровка будет ошибочной, данные будут искажены. На качество влияет также предварительная подготовка женщины и правильность взятия материала. Далее расскажем, что отличает между собой плохой мазок и хороший, и что нужно делать для уточнения причин отклонений.
Результаты мазка
Врачом лаборантом при проведении мазка на флору у женщин в анализе выделения могут быть обнаружены следующие образования:
1. Плоский эпителий - слой клеток, выстилающий влагалище и шейку матки. В норме эпителий должен присутствовать. Отсутствие его в результате мазка свидетельствует об атрофии эпителиальных клеток.
2. Лейкоциты в анализе на флору у женщин - норма до 15 единиц в поле зрения (в мочеиспускательном канале до 5, во влагалище до 10 и в шейке матки до 15 единиц в поле зрения). Количество лейкоцитов в мазке у женщин резко возрастает при воспалении влагалища (кольпит, вагинит). Чем больше лейкоцитов, тем острее протекает заболевание. При остром воспалении значение этого показателя результата мазка на флору будет "до 100 в поле зрения" или "покрывают все поле зрения".
3. Палочки в анализе мазка на флору составляют нормальную микрофлору влагалища. Кроме палочек гинекологический мазок на флору не должен содержать других микроорганизмов.
4. «Ключевые» клетки в мазке - это гарднереллы - возбудители гарднереллеза. Дрожжевые грибы - признак кандидоза (молочницы). В скрытых (бессимптомных) стадиях молочницы грибок в мазке может обнаруживаться в виде спор.
5. Лептотрикс (Leptothrix) - анаэробная грамотрицательная бактерия. Чаще всего лептотрикс встречается при смешанных половых инфекциях - трихомониазе и хламидиозе, при кандидозе и бактериальном вагинозе. Определение его в мазках из влагалища должно настораживать врача и предусматривать дальнейшее более углубленное обследование женщины, чем просто анализ на флору.
6. Мобилункус - анаэробный микроорганизм, один из представителей транзиторной микрофлоры мочеполовых органов. Часто встречается у женщин с бактериальным вагинозом и кандидозом.
7. Трихомонада - простейший микроорганизм, представляет собой подвижный одноклеточный организм со жгутиком, вызывающий воспалительные заболевания мочеполовой сферы.
8. Гонококки (диплококки) - возбудители гонореи - в анализе мазка у здоровых пациенток не определяются.
«Хороший мазок»
Расшифровка хорошего мазка в на флору характеризуется наличием следующих показателей:
- Плоский эпителий - слой клеток, выстилающий влагалище и шейку матки. В нормальном мазке эпителий должен присутствовать. Если же эпителия не содержится, то у гинеколога есть основание предположить недостаток эстрогенов, избыток мужских половых гормонов, атрофию эпителиальных клеток.
- Лейкоциты - норма до 15 - 20 единиц, они препятствуют инфекции в гениталиях. Повышенные лейкоциты в мазке наблюдаются при воспалении (кольпит, вагинит). Чем их больше, тем острее протекает воспаление.
- Золотистый стафилококк в небольших количествах - норма. Значительное повышение может быть симптомом воспалительного процесса во влагалище, слизистой оболочки матки (эндометрит).
- Палочки составляют нормальную микрофлору влагалища. Кроме палочек, в хорошем мазке не должно быть других микроорганизмов.
«Плохой мазок»
Результаты мазка на флору может содержать патологические микроорганизмы, указывающие на наличие той или иной половой инфекции. В расшифровке врач-лаборант может указать следующие бактерии, характерные для "плохого" анализа мазка у женщин:
- Кокки - в отличие от палочек это шаровидные бактерии. Кроме них, могут содержаться диплококки - двойные палочки или гонококки.
- Мелкие палочки - это чаще всего гарднереллы - возбудители гарднереллеза или дисбактериоза влагалища.
- «Ключевые» клетки в мазке (нетипичные, плохие клетки для флоры влагалища) - это фрагменты плоского эпителия, склеенные с мелкой палочкой. Такие мазки мазки - плохие, т.к. содержат ключевые клетки, и гинеколог может поставить диагноз - дисбиоз/гарднереллез.
- Грибок - признак кандидоза (молочницы). В скрытых стадиях грибок может обнаруживаться в виде спор.
- Если в наличии вагинальные трихомонады, есть все основания предположить трихомониаз.
Количество той или иной флоры обозначают знаком «+».
Всего их выделяют 4 категории:
• «+» - величина показателя незначительная;
• «++» - количество показателя умеренное;
• «+++» - увеличенное количество показателя;
• «++++» - завышенное (обильное) количество;
• «abs» - отсутствие того или иного элемента.

Причины плохого мазка на флору и что делать дальше?
Даже если результаты мазка у женщины ;"плохие" - они показывают наличие кокков, мелкой палочки, «ключевых» клеток и т.п, свидетельствующих о неблагополучии флоры, одних только этих данных недостаточно для установления причины и постановки правильного диагноза. Это значит, что женщине потребуется провериться на инфекции стандартными способами - сдать бактериологический посев и анализы ПЦР.
Гинекологические мазки на флору: как берут, что показывают, как расшифровываются

Процедура взятия мазка на флору известна каждой женщине, посетившей смотровой кабинет. Так как анализ позволяет определить микробиологический состав, выявить гормональные нарушения и воспалительные процессы, мазок берётся независимо от того, имеет ли женщина жалобы на здоровье или нет.
СТОИМОСТЬ МАЗКА НА ФЛОРУ В НАШЕЙ КЛИНИКЕ В САНКТ-ПЕТЕРБУРГЕ

*Клиника имеет лицензию на оказание этих услуг
Виды мазков
В зависимости от места взятия, мазки бывают:
- вагинальные (V-vagina);
- с поверхности шейки матки (C-cervix);
- из мочеиспускательного канала (U- uretra).
Как берут мазок из половых органов
С половых губ мазок берётся редко, если только для этого имеются особые показания, например, наличие воспалённых участков. В этом случае мазок заменяют соскобом. Чаще гинекологу нужен влагалищный мазок. Он берётся шпателем из заднего свода влагалища, при воспалении — с видимого участка.
Полученный материал наносится на стекло, подсушивается, сверху наносится несколько капель этанола. Образец маркируется и отправляется в закрытой ёмкости в лабораторию.
При выявлении ИППП (ЗППП) мазок берётся с помощью тампона, который помещается в стерильную пробирку и передаётся на исследование.
Во многих медицинских учреждениях практикуется приём пациенток с одноразовыми диагностическими наборами. Например, часто используется набор «Юнона», предназначенный специально для взятия проб различного характера (венерологические, гинекологические). Все предметы асептично упакованы, и имеют разный состав в зависимости от характера осмотра.
- Набор «Юнона-0» состоит из смотровых перчаток, пелёнки и ложки Фолькмана, которой берётся образец слизистой поверхности влагалища, уретры или шейки матки.
- «Юнона-1» включает вместо ложки Фолькмана зеркало Куско. С его помощью область осмотра увеличивается в 2 раза, можно увидеть отёки, окраску тканей, рубцы. Руки доктора свободны, и он может проводить любую манипуляцию.
- «Юнона №3» имеет как зеркало Куско, так и ложку Фолькмана. Это нужно для того, чтобы была возможность взять мазки как из влагалища, так и из шейки матки или уретры без боязни случайного переноса микрофлоры.
- Набор «Юнона» №4 имеет дополнительно цитощётку, с помощью которой безболезненно берётся мазок из цервикального канала.
- «Юнона-5» дополнена шпателем Эйра с микропорами на конце, с его помощью берётся мазок с любой поверхности. Предметные стёкла нужны для переноса на них материала мазка, но обычно стёкла имеются в каждом смотровом кабинете.
В клинике Диана все одноразовые расходные материалы уже включены в стоимость приема или анализов, поэтому с собой ничего нести не нужно.
Как берут мазок из уретры
Забор мазка из уретры проводится двумя способами:
- Ложка Фолькмана вводится в уретру на несколько сантиметров, делается соскоб эпителиальных клеток путём прижимания аппликатора к стенкам уретры и вращая его в разные стороны. Это довольно болезненная процедура, если имеется травма или воспаление мочеиспускательного канала.
- При сильных выделениях размещать ложку Фолькмана внутрь уретры не нужно. Достаточно надавить а переднюю стенку влагалища, чтобы содержимое мочеиспускательного канала вышло наружу. Затем оно собирается аппликатором и помещается в пробирку.
Как берут мазок из шейки матки
Существует 4 вида мазков из шейки матки:
- исследование на флору;
- обследование на стерильность;
- исследование на скрытые инфекции методом полимеразной цепной реакции;
- ПАП-тест на цитологию.
Мазок на флору из шейки матки выявляет не только болезнетворные бактерии, но и патогенные эпителиальные клетки.
Процедура проводится с помощью зеркала Куско. Это зеркало не в привычном понимании этого слова. Оно больше похоже на прозрачные щипцы, которые раздвигают стенки влагалища, освобождая доступ к шейке матки. Затем шпателем или цитощёткой делается соскоб, по которому оценивается состояние эпителиальных клеток.
Расшифровка результатов анализов гинекологического мазка. Норма
| Показатель | Из влагалища | Их уретры | Из шейки матки |
| Лактобактерии | Палочки Дедерлейна | Нет | Нет |
| Количество палочковой флоры | от + до ++++ | от + до ++++ | от + до ++++ |
| Кандида | до 104 КОЕ/мл | отсутствует | отсутствует |
| Плоский эпителий | 5-10 | 5-10 | 5-10 |
| Лейкоциты | 0-10 | 0-5 | 0-30 |
| Эритроциты | 0-2 | 0-2 | 0-2 |
| Слизь | умеренное количество | отсутствует | умеренное количество |
| Гонококки Gn | отсутствует | отсутствует | отсутствует |
| Трихомонада Trich | отсутствует | отсутствует | отсутствует |
| Ключевые клетки | отсутствуют | отсутствуют | отсутствуют |
Что означают отклонения в мазке из влагалища
Отклонения от нормы в мазке из влагалища говорят о следующем:
Низкое содержание палочек Дедерлейна указывает на плохой микробиоценоз с преобладанием болезнетворной микрофлоры. Палочки Дедерлейна — это вытянутые по форме лактобактерии, которые в качестве продукта жизнедеятельности образуют молочную кислоту. Благодаря им поддерживается кислая среда во влагалище, защищающая от проникновения патогенных микроорганизмов. Молочная кислота активизирует иммунные клетки, ведущие борьбу с микробами.
При снижении числа палочек Дедерлейна у женщины развивается влагалищный дисбактериоз. Это случается во время болезни, гормональной терапии, приёме антибиотиков и гормонов, сильном или затяжном стрессе, заражении ЗППП.
При обнаружении малого количества лактобактерий женщине дополнительно назначают ПАП-тест на скрытые инфекции. Если он не даст положительного ответа, то пациентки прописывают вагинальные свечи, которые подавляют патогенную микрофлору, помогая палочкам Дедерлейна.
Высокое содержание кокковой флоры и снижение палочковый флоры указывает на ослабление иммунитета или активизацию условно-патогенной микрофлоры. Степень чистоты влагалища определяется от нормоциноза до вагинита.
- При 1 степени (нормоценоз) кислотность влагалища составляет рН 3,8 ̶ 4,2, много палочек Дедерлейна, нет лейкоцитов, имеются единичные клетки эпителия.
- При 2 степени чистоты количество лейкоцитов увеличивается до 10, а клеток эпителия имеется довольно много. Кислотность увеличивается до рН 4,0 ̶ 4,5.
- При 3 степени чистоты кислотная среда сменяется слабощелочной (рН 5,0 ̶ 5,5), кокковая микрофлора доминирует над лактобактериями, лейкоциты в пределах норма. 4 степень чистоты лактобактерий нет вообще, среда во влагалище щелочная (рН 6,0 ̶ 6,5). Помимо различных кокков, встречаются единичные трихомонады и ключевые клетки.
Нормальный мазок соответствует 1 и 2-й степеням чистоты. В этом случае «население» слизистой поверхности влагалища должно соответствовать параметрам:
- лактобактерии в количестве 10 7 — 10 9 КОЕ/мл (КОЕ — это одна микробная клетка (колониеобразующая единица), которая в питательной среде активно размножается и образует колонию);
- стрептококки до 10 5 КОЕ/МЛ;
- кандида, клостридии, стафилококки, превотеллы — до 10 4 КОЕ/мл;
- уреаплазма, микоплазма — до 10 3 КОЕ/мл;
При 3 степени чистоты у женщины диагностируется бактериальный вагиноз — нарушение естественного баланса при снижении количества лактобактерий и увеличении содержания грамотрицательных палочек.
Также при 3 и 4 степени чистоты влагалища характерен вагинит (кольпит) — увеличение количества условно-патогенной микрофлоры, сопровождающееся воспалением поверхности влагалища.
Какие патогены и отклонения обнаруживаются в плохих мазках
- Кандида — это грибковое поражение влагалища, уретры или шейки матки, вызванное снижением иммунитета, дисбактериозом влагалища. С заболеванием сталкивалась хотя бы раз каждая женщина. Оно достаточно легко и быстро лечится, но иногда свидетельствует о более серьёзной патологии — сахарном диабете.
- Повышение числа эпителиальный клеток свидетельствует о воспалительном процессе, а полное отсутствие — об атрофии стенок влагалища или дефиците эстрогена. Плоский эпителий -— это отмершие, слущенные с поверхности стенок влагалища слизистые клетки. Они постоянно отпадают, и на их месте зарождаются новые клетки. В норме в мазке не должно быть более 10 эпителиальных клеток.
- Лейкоциты . Это иммунные клетки, которые ведут борьбу с патогенной микрофлорой. В мазке у небеременной женщины их не более 10, у беременной — до 30 штук. Увеличение лейкоцитов выше нормы свидетельствует как о неспецифическом воспалении (при кольпите, вагинозе), так и специфическом (при ИППП). Обязательно нужно найти источник воспаления. Это может быть аднексит (воспаление придатков), эндометрит (воспаление эндометрия), дисбактериоз влагалища, острая форма кандидоза.
- Повышение эритроцитов свидетельствует о сильном воспалении. Эритроциты — это красные кровяные тельца, в норме их количество не должно превышать 2 штуки. Если их больше, это означает, что при соприкосновении цитощётки со стенкой влагалища были повреждены мелкие сосуды. Также число эритроцитов повышается сразу после менструации.
- Большое количество слизи в мазке указывает на воспаление шейки матки, потому что слизь выделяется именно там (влагалище не имеет желез). В норме в сутки у женщины истекает 4 мл слизи. Если она розоватого цвета, и при анализе в ней обнаруживаются лейкоциты, это свидетельствует о воспалении цервикального канала. Также количество слизи увеличивается у беременных женщин.
- Гонококки . Это микроорганизмы, передающиеся половым путём. Этой бактерии в мазке быть не должно. Если к тому же лейкоциты и эритроциты также высоки, то пациентке требуется сдать ПАП-тест и пройти ПРЦ-диагностику на выявление ДНК микроба.
- Трихомонада . Это ИППП, свидетельствующая о заражении трихомониазом. Даже один микроб требует срочного лечения.
- Ключевые клетки указывают на воспалительный процесс, вызванный попаданием внутрь организма ИППП, а также развитием заболеваний детородной системы — эрозии шейки матки, эктопии, полипов эндометрия. Они появляются при изменении кислотной среды влагалища на щелочную. Ключевые клетки (это обычный плоский эпителий, окружённый патогенными микроорганизмами) имеют свойство перерождаться, поэтому при выявлении хотя бы одной из них женщине следует регулярно проходить обследование.
Нормальные показатели мазков из уретры
При взятии мазка из уретры норма мазка является таковой:
- В норме 95% микрофлору уретры должны составлять лактобактерии. Если условно-патогенная микрофлора доминирует, это говорит об ослаблении иммунитета или о болезнях органов малого таза.
- Большое количество плоского эпителия указывает на перенесённые ранее заболевания воспалительного характера (цистит, болезни почек).
- Эритроциты свидетельствуют о сильном отёке, вызванном воспалительном процессе, а также о повреждении мочеиспускательного канала.
- Лейкоциты выше нормы бывают при воспалении, вызванным переохлаждением, падением иммунитета или инфекцией.
- Дрожжи, в частности, кандида, является следствием переноса инфекции из влагалища, когда заболевание достигает серьёзной формы. В норме никаких дрожжей в уретре быть не должно. Как и слизи, появление которой в мочеиспускательном канале указывает на инфицирование.
Чтобы узнать возбудителя инфекции, у пациентки берётся бактериальный посев — лабораторный анализ, позволяющий найти грамотный антибиотик, к которому имеется хорошая чувствительность.
Нормы мазка из цервикального канала
Мазок из цервикального канала и соскоб с шейки матки имеют разное значение.
Соскоб относится к области цитологии — выявление патологического размножения клеток, способных перерождаться или уже переродившихся в рак. Процедуру проводят девушкам старше 18 лет.
Мазок проводится из самого цервикального канала. Для этого с помощью зеркала раздвигаются стенки влагалища, и из канала берётся биоматериал. Процедура довольно неприятная, но очень информативна.
Результаты мазка должны быть такими:
- Эпителий (отмершие клетки слизистой оболочки) возможен, но не более 10 единиц. Если его больше, это говорит о прогрессивном воспалительном процессе, причём не только на шейке матки, но и в фаллопиевых трубах или самой матке.
- Если во влагалище количество лейкоцитов не должно превышать 10 штук, то в цервикальном канале их число увеличивается до 30. Фагоцитоз (повышенная активность лейкоцитов) указывает на активную деятельность болезнетворных бактерий.
- Палочки Дедерлейна в цервикальном канале отсутствуют.
- Слизь вырабатывается желёзками шейки матки, поэтому содержится в небольшом количестве в цервикальном канале
Что делать, если результаты мазка плохие?
Результаты анализов выдаются на руки или приходят лечащему гинекологу. При наличии отклонений от норм, доктор назначает лечение или дополнительную диагностику.
После прохождения курса лечения, нужно ещё раз сдать анализы, чтобы убедиться, что болезнь полностью ушла. Недолеченные заболевания заканчиваются осложнениями и хроническими формами. Хронические заболевания можно только гасить, а вот полностью избавиться от них нельзя.
Главный женский анализ — мазок на флору: просто о сложном

Мазок на флору — биологическую чистоту или микрофлору — это один из главных методов исследования, практикуемых в гинекологии. Материал для такого исследования берётся со слизистых оболочек влагалища, шейки матки и мочеиспускательного канала. Основная задача гинеколога, берущего анализ, — получить информацию о состоянии микрофлоры и наличии возбудителей мочеполовых заболеваний.
В женских половых органах существует множество микроорганизмов, некоторые из них опасны, другие безвредны для организма, пока их мало, третьи и вовсе необходимы для женского здоровья, так как помогают бороться с патогенными бактериями, вызывающими воспалительные процессы. Мазок на флору (мазок на чистоту влагалища) помогает определить состав флоры и качество среды, в которой она обитает.
Что можно обнаружить в мазке на чистоту влагалища?
Мазок на чистоту флоры влагалища может выявить следующие элементы:
- Эпителий . Это отмершие эпителиальные клетки покрывающих органы тканей, в частности влагалища и шейки матки. В норме его должно быть немного. Если в исследуемом образце биоматериала много, значит, в организме протекает воспалительный процесс. Отсутствие эпителия наблюдается у женщин со сбоями в гормональном фоне, при избытке тестостерона и недостатке эстрогена. Это не менее опасный симптом, приводящий к раннему старению организма и снижению половой функции.
- Лейкоциты . Это особенные клетки — защитники от инфекций, вырабатываемые благодаря иммунной системе. Лейкоцитарные клетки имеют белый цвет, поэтому их называют белыми кровяными тельцами. В норме их должно быть небольшое количество, чтобы противостоять атакам болезнетворных бактерий. Признак воспаления — увеличение числа лейкоцитов.
- Эритроциты . Эритроцитные клетки входят в состав крови — это они придают ей красный цвет. Их концентрация в мазке зависит от фазы менструального цикла. Однако если их очень много, можно предположить эрозию, воспаление или повреждение слизистой оболочки влагалища.
- Слизь. Это вязкое вещество выделяют железы влагалища. Благодаря ей происходит самоочищение половых путей. А это значит, что слизь должна обязательно входить в состав мазка на чистоту влагалища. Если слизь обнаружена в мочеиспускательном канале, то это первый признак инфицирования мочевыводящих путей.
- Атипичные клетки . Это клетки, отличающиеся по строению от нормальных. В норме их вообще не должно быть — они являются знаком предракового состояния.
- Гарднереллы . Эти микроорганизмы относятся к условно-патогенной флоре, что означает их безвредность до определенного момента. Именно условная патогенность позволяет им находиться в организме, не вызывая атак иммунной системы. При некоторых обстоятельствах, например, при ослаблении иммунитета или инфицировании другими патогенами, число гарднерелл увеличивается, что приводит к гарднереллезу, который редко протекает в одиночестве. Обнаружение этих микроорганизмов в мазке в небольшом количестве — норма. А вот увеличение числа гарднерелл свидетельствует о дисбактериозе влагалища и бактериальном вагинозе.
- Ключевые клетки. Так называют клетки эпителия, которые склеиваются друг с другом микробами и вирусами. Они появляются при гарднереллезе и слабом иммунитете.
- Кокки. Бактерии шарообразной формы, имеющие патогенный (гонококк) или условно-патогенный (стафилококк) характер. В случае обнаружения кокков патогенов необходимо очень серьезное лечение.
- Кандида . Этот грибок может быть обнаружен в небольшом количестве даже у здоровых женщин. Если кандид больше, чем лактобактерий, то начинается кандидоз или, как называют эту болезнь, «молочница». Так бывает при приеме антибиотиков, беременности и снижении иммунитета.
- Трихомонада . Эту бактерию — возбудителя опасного заболевания трихомониаза, не всегда можно обнаружить при исследовании мазка на чистоту влагалища из-за её способности изменять форму. Для подтверждения её присутствия проводится дополнительный анализ — бактериальный посев (бакпосев). Но если она обнаружена, лечения не избежать.
- Палочки Дондрейна — лактобациллы . Главные женские микроорганизмы, поддерживающие здоровье половой системы. Их присутствие в мазке на чистоту влагалища строго обязательно.
Когда нужно сдавать мазок на флору?
Мазок на флору рекомендуется сдавать при любом посещении гинеколога. К сожалению, многие женские болезни протекают скрыто, поэтому этот анализ просто незаменим. Помимо этого, к сдаче гинекологического мазка на чистоту влагалища имеются прямые показания:
- Воспаления органов малого таза;
- Планирование беременности;
- Болевые ощущения внизу живота;
- Зуд, жжение и неестественные выделения из влагалища;
- Беременность;
- Прием антибиотиков или гормонов;
- Смена полового партнера.
В этих случаях мазок на чистоту влагалища поможет выявить нарушения флоры.
Как правильно подготовиться к взятию мазка на чистоту влагалища?
Перед посещением врача следует выполнить некоторые рекомендации:
- Не пользоваться вагинальными препаратами и спринцеванием;
- На пару дней воздержаться от сексуальных контактов;
- Непосредственно перед сдачей мазка постараться 2-3 часа не мочиться.
Лучше всего пойти на обследование после завершения менструации, дней через 5-6. Непосредственный забор биоматериала у женщины проводит гинеколог при помощи одноразового шпателя. Процедура абсолютно безболезненна.
Как расшифровать анализ — мазок на чистоту влагалища
Расшифровывать анализ может только специалист, имеющий соответствующую квалификацию. Желательно, чтобы это сделал тот же врач, который и брал мазок на анализ. Все показатели врачи обозначают несколькими буквами для краткости. Выглядит это так:
V — влагалище;
C — цервикальный канал шейки матки;
U — мочеиспускательный канал;
L — лейкоциты;
Эп — эпителий;
GN-gonokokkovoi;
Trich — трихомонада.
В здоровом мазке присутствует слизь, что свидетельствует о нормальном уровне pH, и лактобациллы (палочки Додерлейна), составляющие 95% от общей микрофлоры.
Знаком «abs» на бланке результата анализа обозначается отсутствие того или иного составляющего, а знаком «+» — его присутствие.
Читайте также:
- Лабораторная диагностика отогенного сепсиса. Течение отогенного сепсиса
- Дифференциальная диагностика патологического прелиминарного периода. Тактика при патологическом прелиминарном периоде.
- Зависимость глубины дозы излучения в лучевой терапии
- Гепатобластома - диагностика, лечение
- Лечение сердечной астмы. Терапия острой сердечной недостаточности
